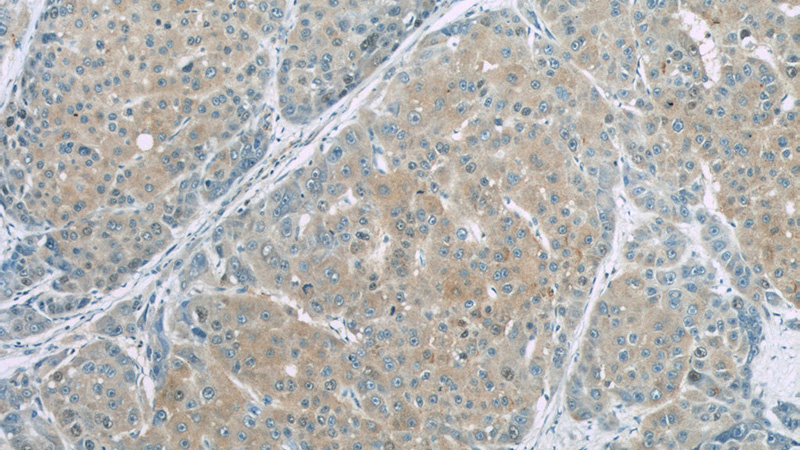
Immunohistochemistry of paraffin-embedded human liver cancer slide using Catalog No:107287(CSE Antibody) at dilution of 1:50

-
Product Name
Gamma cystathionase antibody
- Documents
-
Description
Gamma cystathionase Mouse Monoclonal antibody. Positive IHC detected in human liver cancer tissue. Positive IF detected in HepG2 cells. Positive WB detected in HepG2 cell, HeLa cells, PC-3 cells. Observed molecular weight by Western-blot: 42 kDa
-
Tested applications
ELISA, WB, IHC, IF
-
Species reactivity
Human,Mouse, Rat; other species not tested.
-
Alternative names
CSE antibody; CTH antibody; Cystathionine gamma lyase antibody; Gamma cystathionase antibody
-
Isotype
Mouse IgG1
-
Preparation
This antibody was obtained by immunization of Gamma cystathionase recombinant protein (Accession Number: NM_001902). Purification method: Protein G purified.
-
Clonality
Monoclonal
-
Formulation
PBS with 0.02% sodium azide and 50% glycerol pH 7.3.
-
Storage instructions
Store at -20℃. DO NOT ALIQUOT
-
Applications
Recommended Dilution:
WB: 1:500-1:5000
IHC: 1:20-1:200
IF: 1:20-1:200
-
Validations

HepG2 cells were subjected to SDS PAGE followed by western blot with Catalog No:107287(CSE antibody) at dilution of 1:1000
Immunohistochemistry of paraffin-embedded human liver cancer slide using Catalog No:107287(CSE Antibody) at dilution of 1:50

WB result of CTH antibody (Catalog No:107287, 1:500) with si-control and si-CTH transfected PC-3 cells.

Immunohistochemistry of paraffin-embedded human liver cancer slide using Catalog No:107287(CSE Antibody) at dilution of 1:50

Immunofluorescent analysis of (10% Formaldehyde) fixed HepG2 cells using Catalog No:107287(CSE Antibody) at dilution of 1:50 and Alexa Fluor 488-congugated AffiniPure Goat Anti-Mouse IgG(H+L)
-
Background
CTH, also named as Gamma-cystathionase and CSE, belongs to the trans-sulfuration enzymes family. It catalyzes the last step in the transsulfuration pathway from methionine to cysteine. CTH has broad substrate specificity. It converts cystathionine to cysteine, ammonia and 2-oxobutanoate. And it converts two cysteine molecules to lanthionine and hydrogen sulfide. CTH can also accept homocysteine as substrate. It specificity depends on the levels of the endogenous substrates. It generates the endogenous signaling molecule hydrogen sulfide (H2S), and so contributes to the regulation of blood pressure. (PMID:19261609) The CSE/H2S pathway is upregulated in the heart in a murine model of CVB3-induced myocarditis and that inhibition of endogenous H2S is beneficial to treatment early in the disease while administration of exogenous H2S is protective to infected myocardium during the later stage.(PMID:19695232) Defects in CTH are the cause of cystathioninuria.
Related Products / Services
Please note: All products are "FOR RESEARCH USE ONLY AND ARE NOT INTENDED FOR DIAGNOSTIC OR THERAPEUTIC USE"
